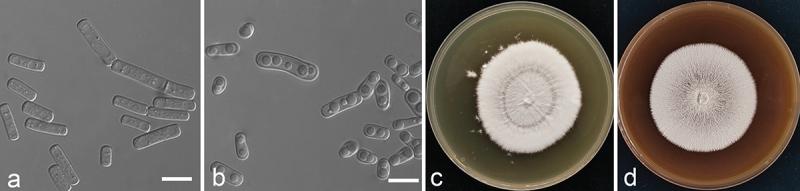
https://cdn.ncbi.nlm.nih.gov/pmc/blobs/b77a/11376286/2aec0a5ceee4/TMYC_A_2294945_F0004_OC.jpg
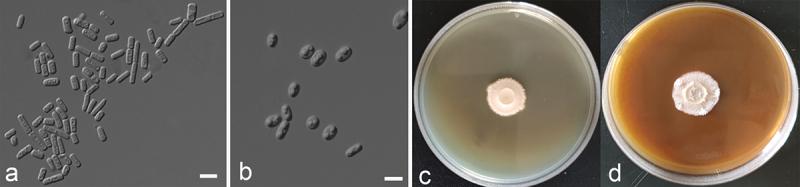
https://cdn.ncbi.nlm.nih.gov/pmc/blobs/b77a/11376286/9da02797f08e/TMYC_A_2294945_F0008_OC.jpg

关于[具体物种1]和[具体物种2]的分类修订,以及来自中国的五个新[具体物种]的描述。
Taxonomic revision of and , with the descriptions of five new species from China.
作者信息
Zhu Hai-Yan, Shang Yu-Jie, Wei Xu-Yang, Groenewald Marizeth, Robert Vincent, Zhang Ri-Peng, Li Ai-Hua, Han Pei-Jie, Ji Fang, Li Jun-Ning, Liu Xin-Zhan, Bai Feng-Yan
机构信息
State Key Laboratory of Mycology, Institute of Microbiology, Chinese Academy of Sciences, Beijing, China.
College of Life Sciences, University of Chinese Academy of Sciences, Beijing, China.
出版信息
Mycology. 2024 Jan 31;15(3):400-423. doi: 10.1080/21501203.2023.2294945. eCollection 2024.
The arthroconidial yeast-like species currently classified in the asexual genera and and the sexual genera , and are frequently associated with dairy and cosmetics production, fruit rot and human infection. However, the taxonomic system of these fungi has not been updated to accommodate the new nomenclature code adopting the "one fungus, one name" principle. Here, we performed phylogenetic analyses of these yeast-like species based on the sequences of the internal transcribed spacer (ITS) region and the D1/D2 domain of the large subunit of the rRNA gene. Two monophyletic groups were recognised from these species. One group contained , , and species and the other and species. We thus assigned the species in each group into one genus and selected the genus name for the first group and for the second one based on the principle of priority of publication. Five new species were identified from arthroconidial yeast strains recently isolated from various sources in China. The new species are described as sp. nov., sp. nov., sp. nov., sp. nov., and sp. nov.
目前归类于无性型属以及有性型属的节孢子酵母样物种,经常与乳制品和化妆品生产、水果腐烂及人类感染相关。然而,这些真菌的分类系统尚未更新以适应采用“一种真菌,一个名称”原则的新命名法规。在此,我们基于核糖体RNA基因大亚基的内转录间隔区(ITS)序列和D1/D2结构域,对这些酵母样物种进行了系统发育分析。从这些物种中识别出两个单系类群。一个类群包含、和物种,另一个包含和物种。因此,我们将每个类群中的物种归入一个属,并根据发表优先权原则,为第一个类群选择属名,为第二个类群选择属名。从中国近期从各种来源分离的节孢子酵母菌株中鉴定出五个新的物种。这些新物种被描述为新种、新种、新种、新种和新种。